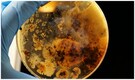

->->Moneycontrol/MC_News/MC_News_Internal_Tags_Native_6|~|Moneycontrol/MC_News/MC_News_Internal_Tags_300x600|~|Moneycontrol/MC_News/MC_News_Internal_Tags_728x90|~|Moneycontrol/MC_News/MC_News_Internal_Tags_300x250_Networth|~|MC_ENG_PWA/MC_ENG_PWA_ROS/MC_ENG_PWA_ROS_AL/MC_ENG_PWA_ROS_AL_PG_slider_1x1|~|Moneycontrol/MC_ROS/MC_ROS_Slider_2x2|~|Moneycontrol_Mobile_WAP/MC_WAP_News/MC_WAP_News_Internal_300x250_Middle_5|~|Moneycontrol_Mobile_WAP/MC_WAP_ROS/MC_WAP_ROS_Audio_1x1|~|Moneycontrol_Mobile_WAP/MC_WAP_News/MC_WAP_News_Internal_Masthead_300x250
Advertisement